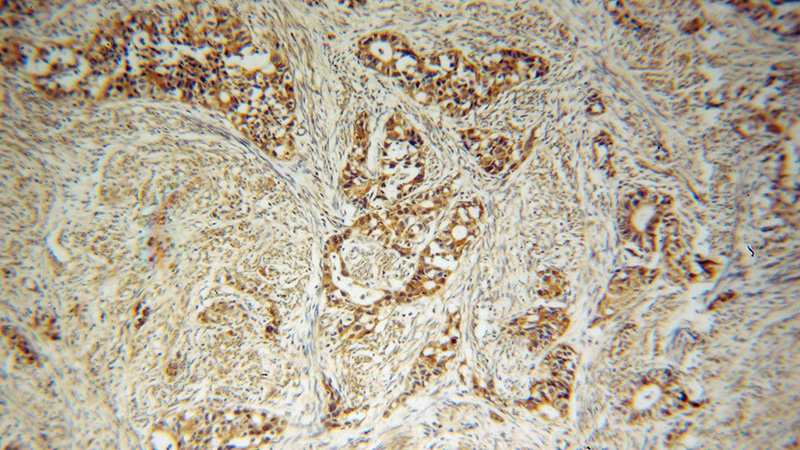
Immunohistochemical of paraffin-embedded human endometrial cancer using Catalog No:107761(ADAM12 antibody) at dilution of 1:100 (under 10x lens)

-
Product Name
ADAM12 antibody
- Documents
-
Description
ADAM12 Rabbit Polyclonal antibody. Positive IF detected in HepG2 cells. Positive IHC detected in human endometrial cancer tissue, human breast cancer tissue, human placenta tissue. Positive IP detected in HeLa cells. Positive WB detected in mouse brain tissue, HeLa cells, human placenta tissue, mouse colon tissue, mouse heart tissue, Y79 cells. Observed molecular weight by Western-blot: 97kd,68kd
-
Tested applications
ELISA, WB, IHC, IF, IP
-
Species reactivity
Human, Mouse; other species not tested.
-
Alternative names
ADAM 12 antibody; ADAM12 antibody; MCMP antibody; MCMPMltna antibody; Meltrin alpha antibody; MLTN antibody; MLTNA antibody
-
Isotype
Rabbit IgG
-
Preparation
This antibody was obtained by immunization of ADAM12 recombinant protein (Accession Number: NM_001288974). Purification method: Antigen affinity purified.
-
Clonality
Polyclonal
-
Formulation
PBS with 0.02% sodium azide and 50% glycerol pH 7.3.
-
Storage instructions
Store at -20℃. DO NOT ALIQUOT
-
Applications
Recommended Dilution:
WB: 1:500-1:5000
IP: 1:200-1:1000
IHC: 1:20-1:200
IF: 1:10-1:100
-
Validations

mouse brain tissue were subjected to SDS PAGE followed by western blot with Catalog No:107761(ADAM12 antibody) at dilution of 1:300

IP Result of anti-ADAM12 (IP:Catalog No:107761, 4ug; Detection:Catalog No:107761 1:300) with HeLa cells lysate 4650ug.
Immunohistochemical of paraffin-embedded human endometrial cancer using Catalog No:107761(ADAM12 antibody) at dilution of 1:100 (under 10x lens)

Immunohistochemical of paraffin-embedded human endometrial cancer using Catalog No:107761(ADAM12 antibody) at dilution of 1:100 (under 40x lens)

Immunofluorescent analysis of HepG2 cells, using ADAM12 antibody Catalog No:107761 at 1:25 and Rhodamine-labeled goat anti-rabbit IgG (red).
-
Background
ADAM12, also named as MLTN and Meltrin-alpha, is involved in skeletal muscle regeneration, specifically at the onset of cell fusion. It is also involved in macrophage-derived giant cells (MGC) and osteoclast formation from mononuclear precursors. ADAM12 is expressed in human malignant tumors. It is involved in the regulation of growth factor activities and integrin functions, leading to promotion of cell growth and invasion, although the precise mechanisms of these are not clear at the present time.(PMID:17355265) ADAM12’s ability to degrade extracellular matrix components likely allows it to detach cancer cells from the basement membrane and assist them on their route to metastasis. But the protein’s role not just as a biomarker of breast cancer but as a gateway to cancer cell migration is only now being understood. This antibody can recognize all isoforms of ADAM12. ADAM12 has 4 forms: 120kd full-length form, 90kd mature(processed form that lack the prodomain);50-68kd degradation product and 27kd prodomain.
-
References
- Roy R, Rodig S, Bielenberg D, Zurakowski D, Moses MA. ADAM12 transmembrane and secreted isoforms promote breast tumor growth: a distinct role for ADAM12-S protein in tumor metastasis. The Journal of biological chemistry. 286(23):20758-68. 2011.
- Fröhlich C, Nehammer C, Albrechtsen R. ADAM12 produced by tumor cells rather than stromal cells accelerates breast tumor progression. Molecular cancer research : MCR. 9(11):1449-61. 2011.
- Rao VH, Kandel A, Lynch D. A positive feedback loop between HER2 and ADAM12 in human head and neck cancer cells increases migration and invasion. Oncogene. 31(23):2888-98. 2012.
- Stautz D, Wewer UM, Kveiborg M. Functional analysis of a breast cancer-associated mutation in the intracellular domain of the metalloprotease ADAM12. PloS one. 7(5):e37628. 2012.
- Fröhlich C, Klitgaard M, Noer JB. ADAM12 is expressed in the tumour vasculature and mediates ectodomain shedding of several membrane-anchored endothelial proteins. The Biochemical journal. 452(1):97-109. 2013.
- Georges S, Chesneau J, Hervouet S. A Disintegrin And Metalloproteinase 12 produced by tumour cells accelerates osteosarcoma tumour progression and associated osteolysis. European journal of cancer (Oxford, England : 1990). 49(9):2253-63. 2013.
- Díaz B, Yuen A, Iizuka S, Higashiyama S, Courtneidge SA. Notch increases the shedding of HB-EGF by ADAM12 to potentiate invadopodia formation in hypoxia. The Journal of cell biology. 201(2):279-92. 2013.
- Aghababaei M, Perdu S, Irvine K, Beristain AG. A disintegrin and metalloproteinase 12 (ADAM12) localizes to invasive trophoblast, promotes cell invasion and directs column outgrowth in early placental development. Molecular human reproduction. 20(3):235-49. 2014.
Related Products / Services
Please note: All products are "FOR RESEARCH USE ONLY AND ARE NOT INTENDED FOR DIAGNOSTIC OR THERAPEUTIC USE"
